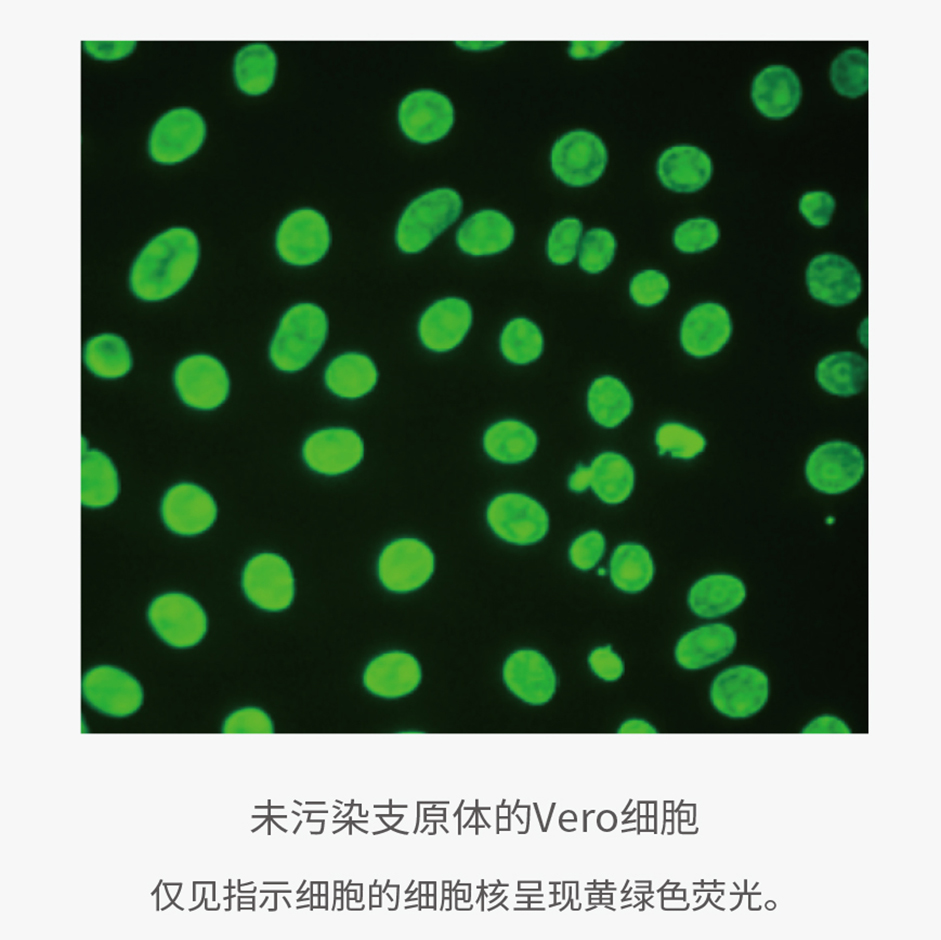
支原体“现形记”：培养、指示、PCR

17 年
手机商铺
入驻年限:17 年
客服部
北京
技术服务、试剂、抗体、细胞库 / 细胞培养、ELISA 试剂盒
生产厂商
公司新闻/正文
456 人阅读发布时间:2024-09-26 13:45
支原体,细胞培养人员的梦魇,堪称细胞培养界的“隐形杀手”。
支原体杀细胞于无形之中。经常悄然潜入细胞培养体系,无声无息的毁掉细胞。除了经验丰富的实验室老手,一般人难以察觉支原体污染。
科研方面,Nature、Cell等期刊高度重视细胞培养实验中的支原体检测信息。目前许多国家有相关的法规,确保源于细胞培养的产品无支原体污染。因此,支原体检测作为生物制品开发生产的重要质控指标,贯穿原材料、细胞库、病毒种子库、终产品等过程。
接下来,我们将全方位归纳支原体污染的知识点,并揭开其神秘面纱,以便我们及时识别和处理支原体污染。
| 防不胜防的支原体 |
支原体(Mycoplasma)是目前发现是最小原核生物,大小为0.1-0.3 μm,可以在过滤膜(0.22-0.45 μm)自由穿梭,即常规过滤除菌对其无效。
支原体无细胞壁,造成大多数抗生素对其无效。抗生素的主要作用机制之一:抑制细胞壁合成。
支原体细胞形态存在差异,有球形、杆状、拉丝、分支等。常规显微镜难观察到支原体的踪迹和内部结构,电子显微镜能观测到。

细胞培养上清液中的支原体污染
(A. 支原体模式图;B. 荧光显微镜下被污染的大鼠细胞,箭头所示为支原体。源自参考文献:doi: 10.3390/cells12050682)
支原体种类繁多,已超过180种,其中20多种能够污染体外培养的细胞。但据统计实验室95%以上的支原体来自这6种:人源的口腔支原体、发酵支原体、人型支原体,牛源的莱氏无胆甾原体和精氨酸支原体,以及猪源的猪鼻支原体。
支原体不能被革兰氏染色,可在琼脂平板上形成“菌落”,并被甲基蓝染色。

支原体在琼脂平板形成的“煎蛋菌落”
(源自参考文献:doi: 10.1038/nprot.2010.43)
支原体分布广泛,附着在器皿表面,不需要寄生,在无生命的培养基中“自由”生长繁殖,因此防不胜防。
| 支原体污染的严重性 |
支原体污染隐蔽性强。污染初期支原体与细胞共存,培养的细胞状态没有明显变化,死亡率也不会增加,培养基不发生浑浊。等发现异常时,可能已经多次传代,难分清是在哪一代出现的污染。导致无法根治,只能从头再来。
支原体污染影响实验结果。支原体抑制细胞生长,导致染色体畸变,细胞抗原性改变,复苏后存活率降低等。支原体污染还会影响细胞代谢和功能,造成细胞蛋白质、DNA、mRNA等合成障碍。

支原体(橙色)可以包围并感染细胞并使基因表达研究的结果无效
(源自参考文献:doi: 10.1038/511518a)
支原体污染增加成本。发现不及时往往意味着大量时间、精力和金钱的浪费,尤其是对于生物制药企业来说更是后果严重。支原体污染可能造成生物制品产量降低、品质下降,甚至整批产品都需丢弃,生产车间也需停产整顿。
细胞库支原体检测是生物制品工艺流程的重中之重。企业在细胞库进入GMP车间前,应做好细胞库支原体和病毒检定,生产过程中完成对细胞收获液的检定。细胞库一旦发生支原体污染,需要开展相应调查,对所有可能风险区域进行清洁,并制定相应预防措施,相应区域无法开展生产工作。因此从细胞株构建开始,就应做好支原体检测,从源头杜绝污染。
| 如何检测支原体 |
细胞培养过程中,出现细胞生长变缓、状态变瘦、细胞黏连、出现拉丝铺展等情况时,可能存在支原体污染。支原体污染可能来自操作人员和细胞培养用原材料如血清和胰蛋白酶,也可能来自于本身已被污染的细胞系和毒种。
支原体污染检测技术常用的有:
1. 直接培养法:将待测样品涂布在支原体固体培养基上,阳性会出现“煎蛋菌落”;
2. 指示细胞法:DNA荧光染色检测法:污染的细胞染色后会看到细胞周围有荧光小点或丝状物;
3. 核酸检测法(NAT):常规PCR、qPCR,根据支原体基因组内的保守序列设计特异引物,对待检样品的核酸进行扩增。
| 检测方法 | 优势 | 劣势 |
| 直接培养法 | 灵敏度高,可达1-10 CFU/mL支原体 | · 培养期长达28天 |
| · 存在漏检风险 | ||
| 指示细胞法 | · 比培养法快 | · 灵敏度较低 |
| · 成本低 | · 不适宜检测粘附较差的口腔支原体和精氨酸支原体 | |
| 核酸检测法(NAT) | · 便捷快速 | · 对样本制备和DNA提取质量依赖性大 |
| · 通量高 | · 需验证与培养法和指示细胞法的可比性 | |
| · 灵敏度高 | ||
| · 特异性好 |
| 义翘神州支原体检测解决方案 |
【1】支原体qPCR检测试剂盒
义翘神州支原体qPCR检测试剂盒(探针法)(货号:MYC01),基于NAT原理,采用FAM、VIC两种荧光探针,分别检测目标序列和内参,可覆盖169种支原体DNA序列。经专属性、检测限、耐用性验证,已支持多个药品申报。
|
义翘神州支原体qPCR检测试剂盒产品特点 ★操作快速: |
| 货号 | 产品名称 | 特色 |
| MYC01 | 支原体qPCR检测试剂盒(探针法) | 覆盖面广、检测限满足要求、耐用性强 |
| RDP01 | 磁珠法残留DNA样本前处理试剂盒 | 配套使用,节约时间和成本 |
产品验证数据展示
专属性:验证充分
►覆盖全面:可检测至少169种(120种支原体,9种脲原体、33种螺原体、7种无胆甾原体),覆盖各国药典要求的10种支原体。
►无样本基质干扰:9种样品基质,1种细胞制剂冻存液,均未检出支原体
►无交叉:16种非柔膜菌纲菌株、12种工程细胞、2种哺乳动物细胞(猪、鼠)。
检测限:满足要求
►口腔支原体10CFU/mL样品的三次检测,8个重复:24个阳性(检测阳性率100%)

耐用性:
►20次冻融,37℃ 加速长达30天,性能不受影响
【2】专业的支原体检测服务
义翘神州建立了北京和苏州双检测中心,通过CMA和CNAS认证,生物安全二级实验室完全按照GxP质量体系管理,配套透射电镜、共聚焦显微镜、荧光定量PCR仪等先进仪器设备。
义翘神州可依据药典方法及ICH、FDA及其它监管法规,为客户提供最佳的检测方案。出具的中英检测报告获得NMPA、FDA等监管部门认可,已助力多家知名公司完成IND和BLA申报。
| 服务类型 | 周期 |
| 支原体检测(培养法) | 6-8周 |
| 支原体检测(DNA染色法) | 6-8周 |
| 支原体检测(qPCR法) | 1-2周 |
| 支原体检测方法学验证 | 2-3月 |
相关案例数据分享
支原体检测服务(培养法)
义翘神州提供符合法规要求的支原体检测服务(培养法),灵敏度符合中国药典要求,肺炎支原体达到10-9,口腔支原体达到10-5。


支原体检测服务(DNA染色法)
义翘神州提供符合法规要求的指示细胞培养法(DNA染色法),如果样品被支原体污染,在荧光显微镜下除细胞外,可见大小不等、不规则的荧光着色颗粒。

【参考文献】
1,Weiskirchen, et al. A Beginner’s Guide to Cell Culture: Practical Advice for Preventing Needless Problems. Cells 2023.
2,Young, et al. Detection of Mycoplasma in cell cultures. Nature Protocols, 2010. doi: 10.1038/nprot.2010.43
3,Callaway, E. Contamination hits cell work. Nature, 2014.